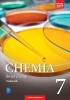

Świat chemii 7 Podręcznik + zeszyt ćwiczeń WSIP PAKIET - Anna Warchoł, Andrzej Danel, Dorota Lewandowska,
Promocja
Świat chemii 7 Podręcznik + zeszyt ćwiczeń WSIP PAKIET - Anna Warchoł, Andrzej Danel, Dorota Lewandowska,
Chemia SP 7 Świat chemii Podr. WSiP
Podręcznik Świat chemii to chemia bez zawiłości ponieważ:
Język przekazu dostosowany do wieku i poziomu umiejętności uczniów ułatwia zrozumienie chemii.
Treść przedzielono śródtytułami w formie pytań, aby wykład budził zaciekawienie. Odpowiedzi na pytania uczeń znajdzie w krótkich blokach tekstu. Taka forma, znana młodzieży z internetu, pozwala na zapoznawanie się z materiałem w odpowiednim tempie i nie wykracza poza możliwości percepcyjne nastolatków.
Każde doświadczenie jest uzupełnione o schematyczny rysunek i barwną fotografię, które w połączeniu z opisem pokazują krok po kroku jego przebieg. Uczniowie dokładnie widzą, co się dzieje podczas doświadczenia, nawet kiedy nie można go przeprowadzić w szkole.
Treść podręcznika odpowiada zapisom nowej podstawy programowej, zawiera wszystkie nowe zagadnienia przez nią wprowadzone, np. pojęcie elektroujemności czy katalizatora.
Część 1 publikacji dotyczy podstaw chemii opisuje: budowę materii i jej rodzaje; oddziaływania, których efektem są wiązania i reakcje chemiczne; substancje chemiczne obecne w atmosferze i hydrosferze.
Konstrukcja publikacji pozwala rozwijać zainteresowanie przedmiotem, m.in. dzięki wprowadzeniu wielu doświadczeń, w tym również do wykonania przez uczniów w domu. Zaproponowano także wiele doświadczeń w tym również do wykonania przez uczniów w domu dzięki czemu uczeń ma szansę kształcić umiejętności praktyczne.
Treść została podzielona na działy, w których znajdują się stałe elementy.
Graficzne wprowadzenie ma zainteresować materiałem omawianym w dziale.
Część główna tematu, podzielona na krótkie fragmenty rozpoczynające się pytaniem, przyciąga uwagę ilustrowanymi schematami i zdjęciami doświadczeń chemicznych.
Podsumowanie zawiera definicje nowych pojęć, które pozwalają szybko przypomnieć sobie najważniejsze terminy poznane podczas lekcji.
Na końcu każdego z tematów, pod hasłem Sprawdź, czy wiesz i rozumiesz, znajdują się pytania i zadania, dzięki którym uczeń oceni, w jakim stopniu zrozumiał problem omawiany w tekście.
W części Dowiedz się więcej zamieszczono pytania i polecenia prowokujące do wyszukiwania wiadomości, które w istotny sposób poszerzą wiedzę ucznia na temat otaczającego go świata.
Domowe laboratorium to propozycje prostych eksperymentów, które UCZEŃ może wykonać w domu za pomocą przedmiotów codziennego użytku, oczywiście PO UZYSKANIU ZGODY RODZICÓW.
Krótkie, ciekawe artykuły Czy wiesz, że z dziedziny ekologii, historii chemii i jej zastosowań mają zainteresować i sprowokować do poszukiwania dodatkowych informacji.
Bogato ilustrowane, zwięzłe Podsumowanie na koniec działu pomaga uporządkować i utrwalić zdobyte wiadomości, w myśl łacińskiej sentencji repetitio est mater studiorum, czyli: powtarzanie jest matką wiedzy.
Test wyboru Sprawdź się składa się z pytań testowych jednokrotnego wyboru (odpowiedzi znajdują się na końcu podręcznika). Uczeń ma możliwość samodzielnej ewaluacji wiedzy przed sprawdzianem.
Wprawki egzaminacyjne zawierają zadania sprawdzające opanowanie zagadnień opisanych w kolejnych punktach podstawy programowej. Nie dotyczą one treści omawianych jedynie w danym rozdziale, lecz pozwalają wracać do wcześniej zdobytych wiadomości i umiejętności.
Działy:
Rodzaje i przemiany materii
Budowa materii
Wiązania i reakcje chemiczne
Gazy
Woda i roztwory wodne
Na końcu każdej części podręcznika zamieszczono Test końcowy, który w klasie 7 składa się z 24 zadań sprawdzających.
Chemia SP 7 Świat chemii ćw. WSiP
Zeszyt ćwiczeń do klasy 7 jest doskonałym uzupełnieniem podręcznika. Wszystkie tytuły działów i rozdziałów są takie same jak w książce.
Rodzaje i przemiany materii
Budowa materii
Wiązania i reakcje chemiczne
Gazy
Woda i roztwory wodne
Zamieszczone w zeszycie ćwiczenia i zadania mają zróżnicowany stopnień trudności i umożliwiają pracę z uczniami na różnych poziomach. Porządkują i utrwalają zdobyte na lekcji wiadomości i umiejętności. Część zadań została zgrupowana w bloki Chemiczne rachunki pozwalają one trenować wykonywanie obliczeń chemicznych.
Każdy dział rozpoczyna się tabelą umiejętności, która ma pomóc uczniowi w planowaniu pracy oraz w dokonaniu samooceny. Zawiera ona wykaz wymagań edukacyjnych, sformułowanych zgodnie z podstawą programową.
Na końcu każdego działu znajdują się zadania podsumowujące, które warto rozwiązać przed lekcją powtórzeniową. Wśród nich mapy myśli, których rysowanie sprzyja lepszemu zrozumieniu i zapamiętaniu nowych treści.
Powtórzenie wiadomości i umiejętności znajdujące się na końcu zeszytu zawiera zadania i mapy myśli dotyczące wszystkich zagadnień omawianych w klasie 7.

Bez ryzyka
14 dni na łatwy zwrot

Szeroki asortyment
ponad milion pozycji

Niskie ceny i rabaty
nawet do 50% każdego dnia
W zestawie
Niepotwierdzona zakupem
Ocena: /5
Kod producenta
9788302168765_9788302168772

Chemia SP 7 Świat chemii Podr. WSiP
Podręcznik Świat chemii to chemia bez zawiłości ponieważ:
Język przekazu dostosowany do wieku i poziomu umiejętności uczniów ułatwia zrozumienie chemii.
Treść przedzielono śródtytułami w formie pytań, aby wykład budził zaciekawienie. Odpowiedzi na pytania uczeń znajdzie w krótkich blokach tekstu. Taka forma, znana młodzieży z internetu, pozwala na zapoznawanie się z materiałem w odpowiednim tempie i nie wykracza poza możliwości percepcyjne nastolatków.
Każde doświadczenie jest uzupełnione o schematyczny rysunek i barwną fotografię, które w połączeniu z opisem pokazują krok po kroku jego przebieg. Uczniowie dokładnie widzą, co się dzieje podczas doświadczenia, nawet kiedy nie można go przeprowadzić w szkole.
Treść podręcznika odpowiada zapisom nowej podstawy programowej, zawiera wszystkie nowe zagadnienia przez nią wprowadzone, np. pojęcie elektroujemności czy katalizatora.
Część 1 publikacji dotyczy podstaw chemii opisuje: budowę materii i jej rodzaje; oddziaływania, których efektem są wiązania i reakcje chemiczne; substancje chemiczne obecne w atmosferze i hydrosferze.
Konstrukcja publikacji pozwala rozwijać zainteresowanie przedmiotem, m.in. dzięki wprowadzeniu wielu doświadczeń, w tym również do wykonania przez uczniów w domu. Zaproponowano także wiele doświadczeń w tym również do wykonania przez uczniów w domu dzięki czemu uczeń ma szansę kształcić umiejętności praktyczne.
Treść została podzielona na działy, w których znajdują się stałe elementy.
Graficzne wprowadzenie ma zainteresować materiałem omawianym w dziale.
Część główna tematu, podzielona na krótkie fragmenty rozpoczynające się pytaniem, przyciąga uwagę ilustrowanymi schematami i zdjęciami doświadczeń chemicznych.
Podsumowanie zawiera definicje nowych pojęć, które pozwalają szybko przypomnieć sobie najważniejsze terminy poznane podczas lekcji.
Na końcu każdego z tematów, pod hasłem Sprawdź, czy wiesz i rozumiesz, znajdują się pytania i zadania, dzięki którym uczeń oceni, w jakim stopniu zrozumiał problem omawiany w tekście.
W części Dowiedz się więcej zamieszczono pytania i polecenia prowokujące do wyszukiwania wiadomości, które w istotny sposób poszerzą wiedzę ucznia na temat otaczającego go świata.
Domowe laboratorium to propozycje prostych eksperymentów, które UCZEŃ może wykonać w domu za pomocą przedmiotów codziennego użytku, oczywiście PO UZYSKANIU ZGODY RODZICÓW.
Krótkie, ciekawe artykuły Czy wiesz, że z dziedziny ekologii, historii chemii i jej zastosowań mają zainteresować i sprowokować do poszukiwania dodatkowych informacji.
Bogato ilustrowane, zwięzłe Podsumowanie na koniec działu pomaga uporządkować i utrwalić zdobyte wiadomości, w myśl łacińskiej sentencji repetitio est mater studiorum, czyli: powtarzanie jest matką wiedzy.
Test wyboru Sprawdź się składa się z pytań testowych jednokrotnego wyboru (odpowiedzi znajdują się na końcu podręcznika). Uczeń ma możliwość samodzielnej ewaluacji wiedzy przed sprawdzianem.
Wprawki egzaminacyjne zawierają zadania sprawdzające opanowanie zagadnień opisanych w kolejnych punktach podstawy programowej. Nie dotyczą one treści omawianych jedynie w danym rozdziale, lecz pozwalają wracać do wcześniej zdobytych wiadomości i umiejętności.
Działy:
Rodzaje i przemiany materii
Budowa materii
Wiązania i reakcje chemiczne
Gazy
Woda i roztwory wodne
Na końcu każdej części podręcznika zamieszczono Test końcowy, który w klasie 7 składa się z 24 zadań sprawdzających.
Chemia SP 7 Świat chemii ćw. WSiP
Zeszyt ćwiczeń do klasy 7 jest doskonałym uzupełnieniem podręcznika. Wszystkie tytuły działów i rozdziałów są takie same jak w książce.
Rodzaje i przemiany materii
Budowa materii
Wiązania i reakcje chemiczne
Gazy
Woda i roztwory wodne
Zamieszczone w zeszycie ćwiczenia i zadania mają zróżnicowany stopnień trudności i umożliwiają pracę z uczniami na różnych poziomach. Porządkują i utrwalają zdobyte na lekcji wiadomości i umiejętności. Część zadań została zgrupowana w bloki Chemiczne rachunki pozwalają one trenować wykonywanie obliczeń chemicznych.
Każdy dział rozpoczyna się tabelą umiejętności, która ma pomóc uczniowi w planowaniu pracy oraz w dokonaniu samooceny. Zawiera ona wykaz wymagań edukacyjnych, sformułowanych zgodnie z podstawą programową.
Na końcu każdego działu znajdują się zadania podsumowujące, które warto rozwiązać przed lekcją powtórzeniową. Wśród nich mapy myśli, których rysowanie sprzyja lepszemu zrozumieniu i zapamiętaniu nowych treści.
Powtórzenie wiadomości i umiejętności znajdujące się na końcu zeszytu zawiera zadania i mapy myśli dotyczące wszystkich zagadnień omawianych w klasie 7.
Niepotwierdzona zakupem
Ocena: /5
Zapytaj o produkt
Niepotwierdzona zakupem
Ocena: /5
Napisz swoją opinię